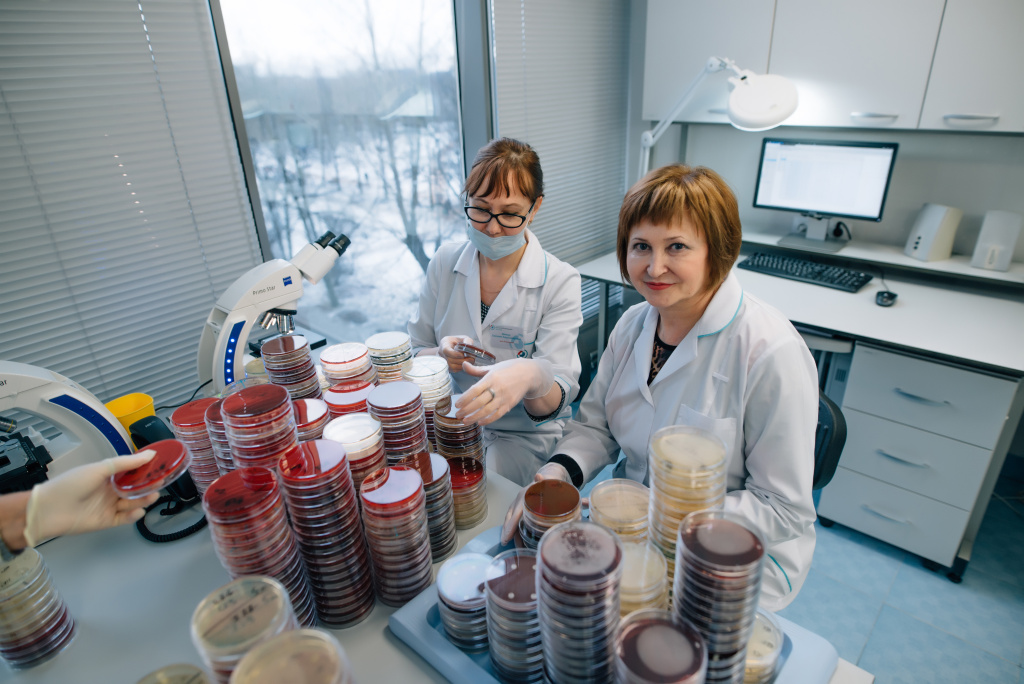
микробиология.jpg

Лаборатория АО "СЗЦДМ"
Лаборатория - сердце Северо-Западного Центра доказательной медицины
Собственная лаборатория Северо-Западного центра доказательной медицины занимает 2200 кв.м. и располагается на 3 и 4 этаже бизнес-центра «Pulkovo Star». Местоположение бизнес-центра на Пулковском шоссе, вблизи основных транспортных магистралей города и аэропорта, позволяет максимально быстро осуществлять доставку биоматериала из любых точек Северо-Запада.
В 2020 году нами были реализованы планы по модернизации лаборатории, а именно установке системы FAST TRACK. Этот проект вывел лабораторию на новый уровень развития. В систему тотальной автоматизации встроен огромный парк оборудования.
Сегодня выполнение исследований проводится на биохимических, иммунохимических, гематологических анализаторах известных производителей, которые отлично зарекомендовали себя в клинико-диагностических лабораториях в РФ и за рубежом. В качестве реактивов используются только проверенные наборы производителей оборудования, имеющие регистрационные удостоверения в РФ.
Все приборы характеризуются высоким качеством исследований, отличной чувствительностью и воспроизводимостью анализа:
- Beckman Coulter (США)
- Abbott (США)
- ROCHE (Швейцария)
- DiaSorin (Италия)
- Thermo Fisher (США)
- Fadia (Швеция)
- Shimadzu (Япония)
- Alifax (Италия)
- Sysmex (Япония)
- SEBIA (Франция)
- Immucor (США)
- TECAN (Швейцария)
- ДНК-Технологии (Россия)
- Bio-Rad (США)

Весь лабораторный комплекс представлен тремя блоками:
В основном зале лаборатории установлена трековая линия POWER EXPRESS производства Beckman Coulter, которая позволяет полностью автоматизировать процессы сортировки и центрифугирования пробирок, аналитического этапа и архивации проб.
Линия трека соединяет анализаторы для выполнения биохимических, иммунохимических и гематологических исследований. Автоматизация процессов позволяет исключить возможность ошибок и минимизировать время выполнения исследований.

С момента запуска лаборатория постоянно оснащается оборудованием лучших мировых производителей Это позволяет нам выполнять широкий спектр исследований и обеспечить наивысшее качество и точность результатов.
Производственный процесс в микробиологической лаборатории включает в себя приготовление и автоматизированный розлив сред, посев микроорганизмов, выращивание и идентификацию, а также определение антибиотикорезистентности и чувствительности к антимикотикам.
Для получения наивысших результатов мы используем аппараты экспертного уровня
- Разливочные модули bioMerieux (Франция)
- Средоварки Masterclave 528 (Anoxomat, Shellab,США),
- Анализаторы (WalkAway, США)
Для выделения, культивирования, накопления и сохранения микроорганизмов в лаборатории используются питательные среды компании Oxoid. Приготовление и розлив сред осуществляется автоматически: при помощи оборудования Masterclave BIOMERIEUX, обеспечивающего стандартизацию процесса средоварения, что обеспечивает высокое качество сред в соответствии с надлежащей лабораторной практикой.
Идентификация микроорганизмов с точностью до подвида всего за несколько секунд достигается за счет использования масс-спектрометрии
Для быстрой обработки всех потоков исследований в микробиологической лаборатории АО «СЗЦДМ» установлено 3 масс-спектрометра Microflex BRUKER. Масс-спектрометры позволяют подтвердить точность данных, которые врачи в других лабораториях могут оценить в буквальном смысле «на глаз».
Кроме диагностических задач, позволяющих лечащим врачам выявить возбудителя и рационально подобрать антимикробную терапию, лаборатория выполняет важную функцию по предотвращению и распространению инфекций, осуществляя бактериологический контроль объектов окружающей среды, медицинских инструментов, одежды и рук медицинского персонала ЛПУ.
Бактериологическая лаборатория АО «СЗЦДМ» является крупнейшей в Санкт-Петербурге.
В конце 2016 – начале 2017 годов на базе лабораторных отделов АО «СЗЦДМ» была создана испытательная лаборатория с целью выполнения исследований/испытаний проб из объектов внешней среды в рамках производственного контроля. В апреле 2017 года Испытательная лаборатория успешно прошла процедуру аккредитации в Национальной системе аккредитации на соответствие требованиям ГОСТ 17025-2009 и, соответственно, вошла в реестр аккредитованных лиц Федеральной службы Росаккредитации.
В область аккредитации испытательной лаборатории входят санитарно-бактериологические, санитарно-химические методы исследований, а так же измерения физических факторов внешней среды.
Лаборатория оснащена современным оборудованием, позволяющим частично автоматизировать этапы исследовательских процессов и, таким образом, сокращать сроки их выполнения, улучшать качество и, как следствие, достоверность полученных результатов.
Так, быстрая и точная идентификация микроорганизмов обеспечивается надежным экспресс-методом с использованием масс-спектрометра Bruker Microflex; использование системы автоматизированного гемокультивирования BACTEC 9050 (для определения стерильности крови) значительно сокращает сроки получения результатов; система Anoxomat обеспечивает превосходную высеиваемость строгих анаэробов.
Выберите свой план работы:
Выездная служба
- Наши специалисты приезжают к Вам и отбирают пробы самостоятельно.
- Заполняют всю необходимую сопроводительную документацию.
- Транспортируют пробы в лабораторию.
- Мы исследуем пробы в лаборатории.
- По готовности сразу же отправляем Вам сканы бланков результатов.
Самостоятельно
- Мы отправляем Вам весь расходный материал и инструкции по отбору проб.
- Консультируем Вас по правилам отбора образцов.
- Вы самостоятельно отбираете пробы и заполняете сопроводительную документацию.
- Отправляете пробы в лабораторию (при помощи нашей транспортной службы).
- Мы исследуем пробы в лаборатории.
- По готовности сразу же отправляем Вам сканы бланков результатов.
Контроль качества
В лаборатории АО «СЗЦДМ» ежедневно проводится внутрилабораторный контроль качества с помощью специального програмного обеспечения, позволяющего проводить контроль качества с помощью методологии «Шесть сигм», «Дельта-чек» по результатам исследований пациентов, «Скользящее среднее», «XB-анализ» с возможностью проведения автоматической верификации и формированием правил автоматической валидации тестов.
Ежедневно в лаборатории формируются отчеты для отправки в международную программу Bio-Rad Unity (США), целью которой является межлабораторное сличение как в рамках нашей компании, так и оперативное сравнение с данными по всем приборам мира.
Наряду с этим проводится ежемесячное участие в программах внешней оценки качества, таких как:
- EQAS — External Quality Assurance Services (Bio-Rad, США),
- RIQAS — International Quality Assessment Scheme (Randox, Великобритания),
- ФСВОК (Федеральная служба внешней оценки качества, Россия).